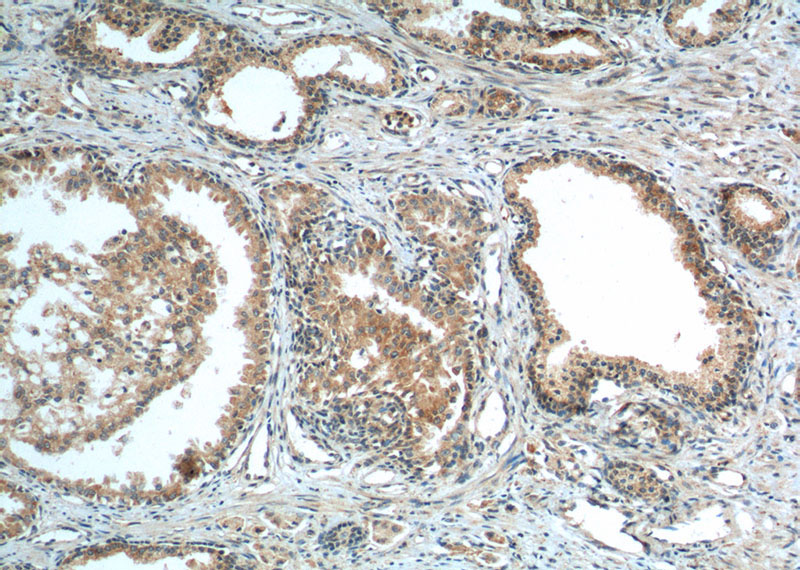
Immunohistochemistry of paraffin-embedded human prostate cancer tissue slide using Catalog No:109662(Cyclin B1 Antibody) at dilution of 1:50 (under 10x lens). heat mediated antigen retrieved with Tris-EDTA buffer(pH9).
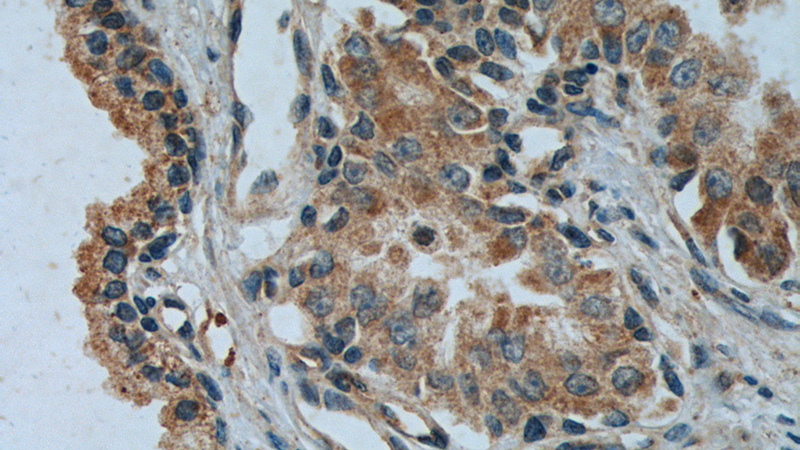
Immunohistochemistry of paraffin-embedded human prostate cancer tissue slide using Catalog No:109662(Cyclin B1 Antibody) at dilution of 1:50 (under 40x lens). heat mediated antigen retrieved with Tris-EDTA buffer(pH9).

-
Product Name
Cyclin B1 antibody
- Documents
-
Description
Cyclin B1 Rabbit Polyclonal antibody. Positive WB detected in HepG2 cells, HeLa cells, Jurkat cells, K-562 cells, PC-3 cells. Positive IP detected in HeLa cells. Positive IF detected in HeLa cells. Positive IHC detected in human prostate cancer tissue, human breast cancer tissue. Observed molecular weight by Western-blot: 55-60 kDa
-
Tested applications
ELISA, WB, IP, IF, IHC
-
Species reactivity
Human,Mouse,Rat; other species not tested.
-
Alternative names
CCNB antibody; CCNB1 antibody; cyclin B1 antibody; G2/mitotic specific cyclin B1 antibody
-
Isotype
Rabbit IgG
-
Preparation
This antibody was obtained by immunization of Peptide (Accession Number: NM_031966). Purification method: Antigen affinity purified.
-
Clonality
Polyclonal
-
Formulation
PBS with 0.02% sodium azide and 50% glycerol pH 7.3.
-
Storage instructions
Store at -20℃. DO NOT ALIQUOT
-
Applications
Recommended Dilution:
WB: 1:500-1:5000
IP: 1:200-1:2000
IHC: 1:20-1:200
IF: 1:20-1:200
-
Validations

HepG2 cells were subjected to SDS PAGE followed by western blot with Catalog No:109662(CCNB1 antibody) at dilution of 1:500

IP Result of anti-Cyclin B1 (IP:Catalog No:109662, 4ug; Detection:Catalog No:109662 1:500) with HeLa cells lysate 1200ug.
Immunohistochemistry of paraffin-embedded human prostate cancer tissue slide using Catalog No:109662(Cyclin B1 Antibody) at dilution of 1:50 (under 10x lens). heat mediated antigen retrieved with Tris-EDTA buffer(pH9).
Immunohistochemistry of paraffin-embedded human prostate cancer tissue slide using Catalog No:109662(Cyclin B1 Antibody) at dilution of 1:50 (under 40x lens). heat mediated antigen retrieved with Tris-EDTA buffer(pH9).

Immunofluorescent analysis of HeLa cells using Catalog No:109662(Cyclin B1 Antibody) at dilution of 1:50 and Alexa Fluor 488-congugated AffiniPure Goat Anti-Rabbit IgG(H+L)
-
Background
Cyclin B1 is a regulatory protein involved in mitosis. The gene product complexes with p34(cdc2) to form the maturation-promoting factor (MPF). Two alternative transcripts have been found, a constitutively expressed transcript and a cell cycle-regulated transcript, that is expressed predominantly during G2/M phase of the cell cycle. The different transcripts result from the use of alternate transcription initiation sites. The antibody is specific to CCNB1.
-
References
- Zheng L, Wang X, Luo W, Zhan Y, Zhang Y. Brucine, an effective natural compound derived from nux-vomica, induces G1 phase arrest and apoptosis in LoVo cells. Food and chemical toxicology : an international journal published for the British Industrial Biological Research Association. 58:332-9. 2013.
- Meng X, Wang X, Tian X, Yang Z, Li M, Zhang C. Protection of neurons from high glucose-induced injury by deletion of MAD2B. Journal of cellular and molecular medicine. 18(5):844-51. 2014.
- Chen H, Xu L, Yin L. iTRAQ-based proteomic analysis of dioscin on human HCT-116 colon cancer cells. Proteomics. 14(1):51-73. 2014.
- Liu Z, Yang L, Teng X, Zhang H, Guan H. The involvement of CXCR7 in modulating the progression of papillary thyroid carcinoma. The Journal of surgical research. 191(2):379-88. 2014.
- Dai B, Zhan Y, Qi J, Zhang Y. Eupolyphaga sinensis Walker inhibits human chronic myeloid leukemia cell K562 growth by inducing G2-M phase cell cycle arrest and targeting EGFR signaling pathway and in S180 tumor-bearing mice. Environmental toxicology and pharmacology. 37(3):1177-85. 2014.
- Zhang Y, Zhan Y, Zhang D. Eupolyphaga sinensis walker displays inhibition on hepatocellular carcinoma through regulating cell growth and metastasis signaling. Scientific reports. 4:5518. 2014.
- Li X, Liu X, Xu Y. KLF5 promotes hypoxia-induced survival and inhibits apoptosis in non-small cell lung cancer cells via HIF-1α. International journal of oncology. 45(4):1507-14. 2014.
- Chen X, Meng Q, Wang C. Protective effects of calycosin against CCl4-induced liver injury with activation of FXR and STAT3 in mice. Pharmaceutical research. 32(2):538-48. 2015.
Related Products / Services
Please note: All products are "FOR RESEARCH USE ONLY AND ARE NOT INTENDED FOR DIAGNOSTIC OR THERAPEUTIC USE"
